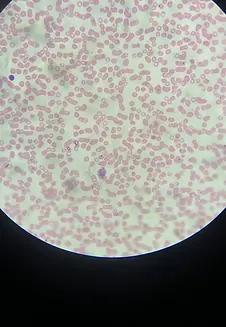
41.webp

NOVEMBRO 2025
EXPERIÊNCIAS
As BEsAESC participaram na Semana da Ciência e Tecnologia do AESC 2025 promovendo, em conjunto com o Departamento de Matemática, Ciências Experimentais e Tecnológicas, uma experiência laboratorial inspirada numa atividade do projeto da RBE - Newton gostava de ler!
A atividade "O pH das Flores" foi desenvolvida pelos professores de Física e Química que tiveram a gentileza de preparar os materiais e explicar aos alunos os passos a seguir.
Em que consistia a atividade?
Oa alunos tinham de preparar a essência de rosa:
1. Cortar as pétalas de rosa em pequenos pedaços
2. Colocar álcool etílico num almofariz
3. Macerar até obter uma solução rosa
4. Filtro o extrato obtido
5. Prepara tubos de ensaio, devidamente numerados, com a adição de um pouco do extrato obtido e 2cm de água
6. Escolher diversas substâncias, como: vinagre, ácido bórico, sal de cozinha, bicarbonato de sódio, limpa-vidros.
Consoante o líquido que adicionavam, a cor da essência variava na escala de pH. Deste modo, foi possível verificar o grau de acidez dos líquidos introduzidos.



Alunos envolvidos na decoração:
Rita Calado
(autora da imagem de fundo)
Rita Corte-Real
(autora do banner da Semana da Ciência e Tecnologia)








As BEsAESC agradecem a participação e orientação dos professores Ana Cristina Pires, Ana Cristina Mendes e José Rui Ferreira.
Enquanto a atividade decorria, a rádio da escola difundia a leitura de poemas de António Gedeão por alunos do AESC.
Atividade que merece nova divulgação.
EXPERIÊNCIAS
Outras experiências foram desenvolvidas:
Vários microscópios foram dispostos no átrio para analisar diferentes materiais.
Atividade desenvolvida pelas professoras de Biologia e de Ciências Naturais.

EXPERIÊNCIAS
Os professores de Matemática apresentaram diversas atividades lúdicas que espevitaram a curiosidade doe alunos.
O Grupo de Matemática apresentou uma atividade na MEDIATECA em colaboração direta com as BEsAESC.
O resumo dessa experiência foi projetada para que todos os alunos da ESMF pudessem assistir.

